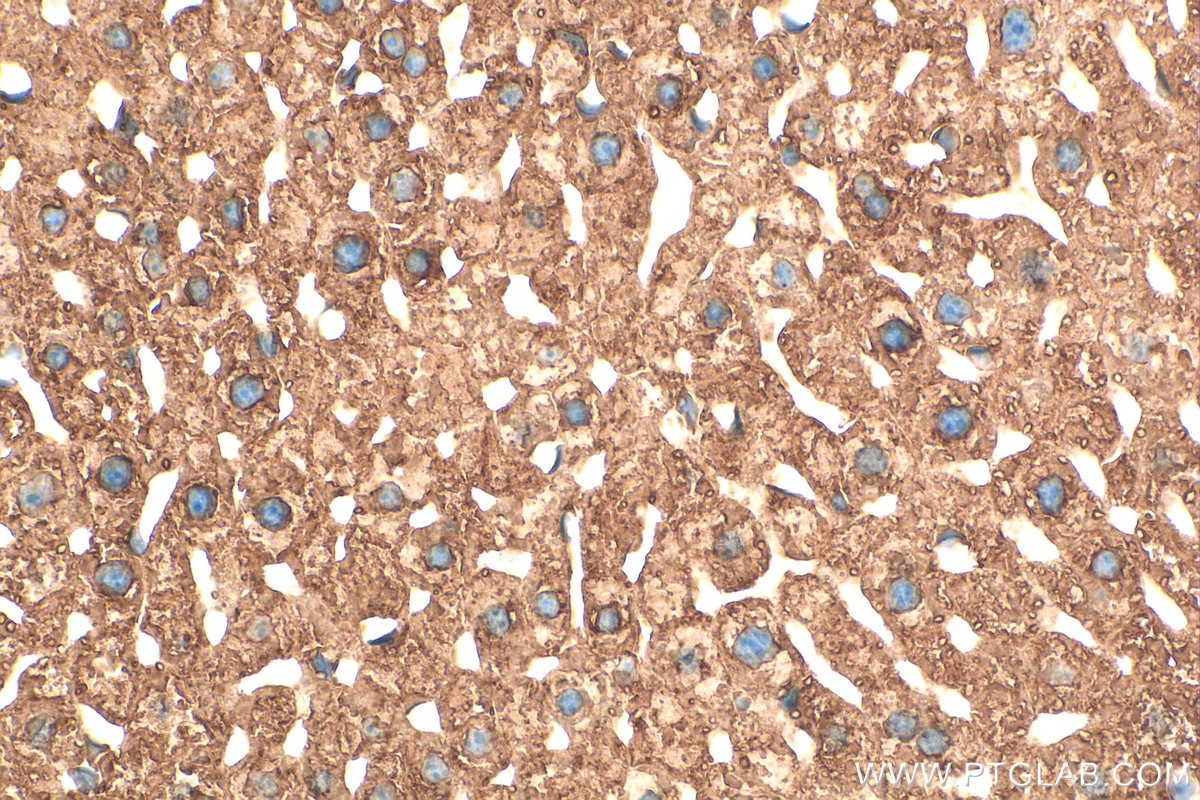
Immunohistochemical analysis of paraffin-embedded mouse liver tissue slide using 11245-1-AP (PDI antibody) at dilution of 1:200 (under 40x lens). Heat mediated antigen retrieval with Tris-EDTA buffer (pH 9.0). Immunohistochemistry (IHC) staining of mouse liver tissue using PDI Polyclonal antibody (11245-1-AP)

Validation Data Gallery
Tested Applications
| Positive WB detected in | COLO 320 cells, HEK-293 cells, HepG2 cells, mouse heart tissue, rat brain tissue |
| Positive IP detected in | HepG2 cells |
| Positive IHC detected in | human prostate cancer tissue, human colon tissue, mouse liver tissue Note: suggested antigen retrieval with TE buffer pH 9.0; (*) Alternatively, antigen retrieval may be performed with citrate buffer pH 6.0 |
| Positive IF/ICC detected in | HepG2 cells |
| Positive FC (Intra) detected in | HeLa cells |
Recommended dilution
| Application | Dilution |
|---|---|
| Western Blot (WB) | WB : 1:2000-1:16000 |
| Immunoprecipitation (IP) | IP : 0.5-4.0 ug for 1.0-3.0 mg of total protein lysate |
| Immunohistochemistry (IHC) | IHC : 1:50-1:500 |
| Immunofluorescence (IF)/ICC | IF/ICC : 1:200-1:800 |
| Flow Cytometry (FC) (INTRA) | FC (INTRA) : 0.40 ug per 10^6 cells in a 100 µl suspension |
| It is recommended that this reagent should be titrated in each testing system to obtain optimal results. | |
| Sample-dependent, Check data in validation data gallery. | |
Published Applications
| KD/KO | See 4 publications below |
| WB | See 41 publications below |
| IHC | See 12 publications below |
| IF | See 21 publications below |
Product Information
11245-1-AP targets PDI in WB, IHC, IF/ICC, FC (Intra), IP, ELISA applications and shows reactivity with human, mouse, rat, zebrafish samples.
| Tested Reactivity | human, mouse, rat, zebrafish |
| Cited Reactivity | human, mouse, rat, pig, monkey, bovine |
| Host / Isotype | Rabbit / IgG |
| Class | Polyclonal |
| Type | Antibody |
| Immunogen |
CatNo: Ag1747 Product name: Recombinant human PDI protein Source: e coli.-derived, PGEX-4T Tag: GST Domain: 89-273 aa of BC014504 Sequence: MTKYKPESEELTAEWITEFCHRFLEGKIKPHLMSQELPEDWDKQPVKVLVGKNFEDVAFDEKKNVFVEFYAPWCGHCKQLAPIWDKLGETYKDHENIVIAKMDSTANEVEAVKVHSFPTLKFFPASADRTVIDYNGERTLDGFKKFLESGGQDGAGDDDDLEDLEEAEEPDMEEDDDQKAVKDEL 相同性解析による交差性が予測される生物種 |
| Full Name | prolyl 4-hydroxylase, beta polypeptide |
| Calculated molecular weight | 57 kDa |
| Observed molecular weight | 57 kDa |
| GenBank accession number | BC014504 |
| Gene Symbol | PDI |
| Gene ID (NCBI) | 5034 |
| RRID | AB_2298937 |
| Conjugate | Unconjugated |
| Form | |
| Form | Liquid |
| Purification Method | Antigen affinity purification |
| UNIPROT ID | P07237 |
| Storage Buffer | PBS with 0.02% sodium azide and 50% glycerol{{ptg:BufferTemp}}7.3 |
| Storage Conditions | Store at -20°C. Stable for one year after shipment. Aliquoting is unnecessary for -20oC storage. |
Background Information
PDIA1(Protein disulfide-isomerase) is also named as ERBA2L, PDI, P4HB, PO4DB. It is a multifunctional protein that catalyzes the formation, breakage and rearrangement of disulfide bonds. In some cell types, it seems to be secreted or associated with the plasma membrane, where it undergoes constant shedding and replacement from intracellular sources.It can exsit as homodimer and monomers and homotetramers may also occur(PMID:12095988).
Protocols
| Product Specific Protocols | |
|---|---|
| FC protocol for PDI antibody 11245-1-AP | Download protocol |
| IF protocol for PDI antibody 11245-1-AP | Download protocol |
| IHC protocol for PDI antibody 11245-1-AP | Download protocol |
| IP protocol for PDI antibody 11245-1-AP | Download protocol |
| WB protocol for PDI antibody 11245-1-AP | Download protocol |
| Standard Protocols | |
|---|---|
| Click here to view our Standard Protocols |
Publications
| Species | Application | Title |
|---|---|---|
J Thromb Haemost VWF-Gly2752Ser, a novel non-cysteine substitution variant in the CK domain, exhibits severe secretory impairment by hampering C-terminal dimer formation. | ||
Mol Cell The oncomicropeptide APPLE promotes hematopoietic malignancy by enhancing translation initiation. | ||
J Extracell Vesicles Extracellular vesicles derived from oesophageal cancer containing P4HB promote muscle wasting via regulating PHGDH/Bcl-2/caspase-3 pathway. |